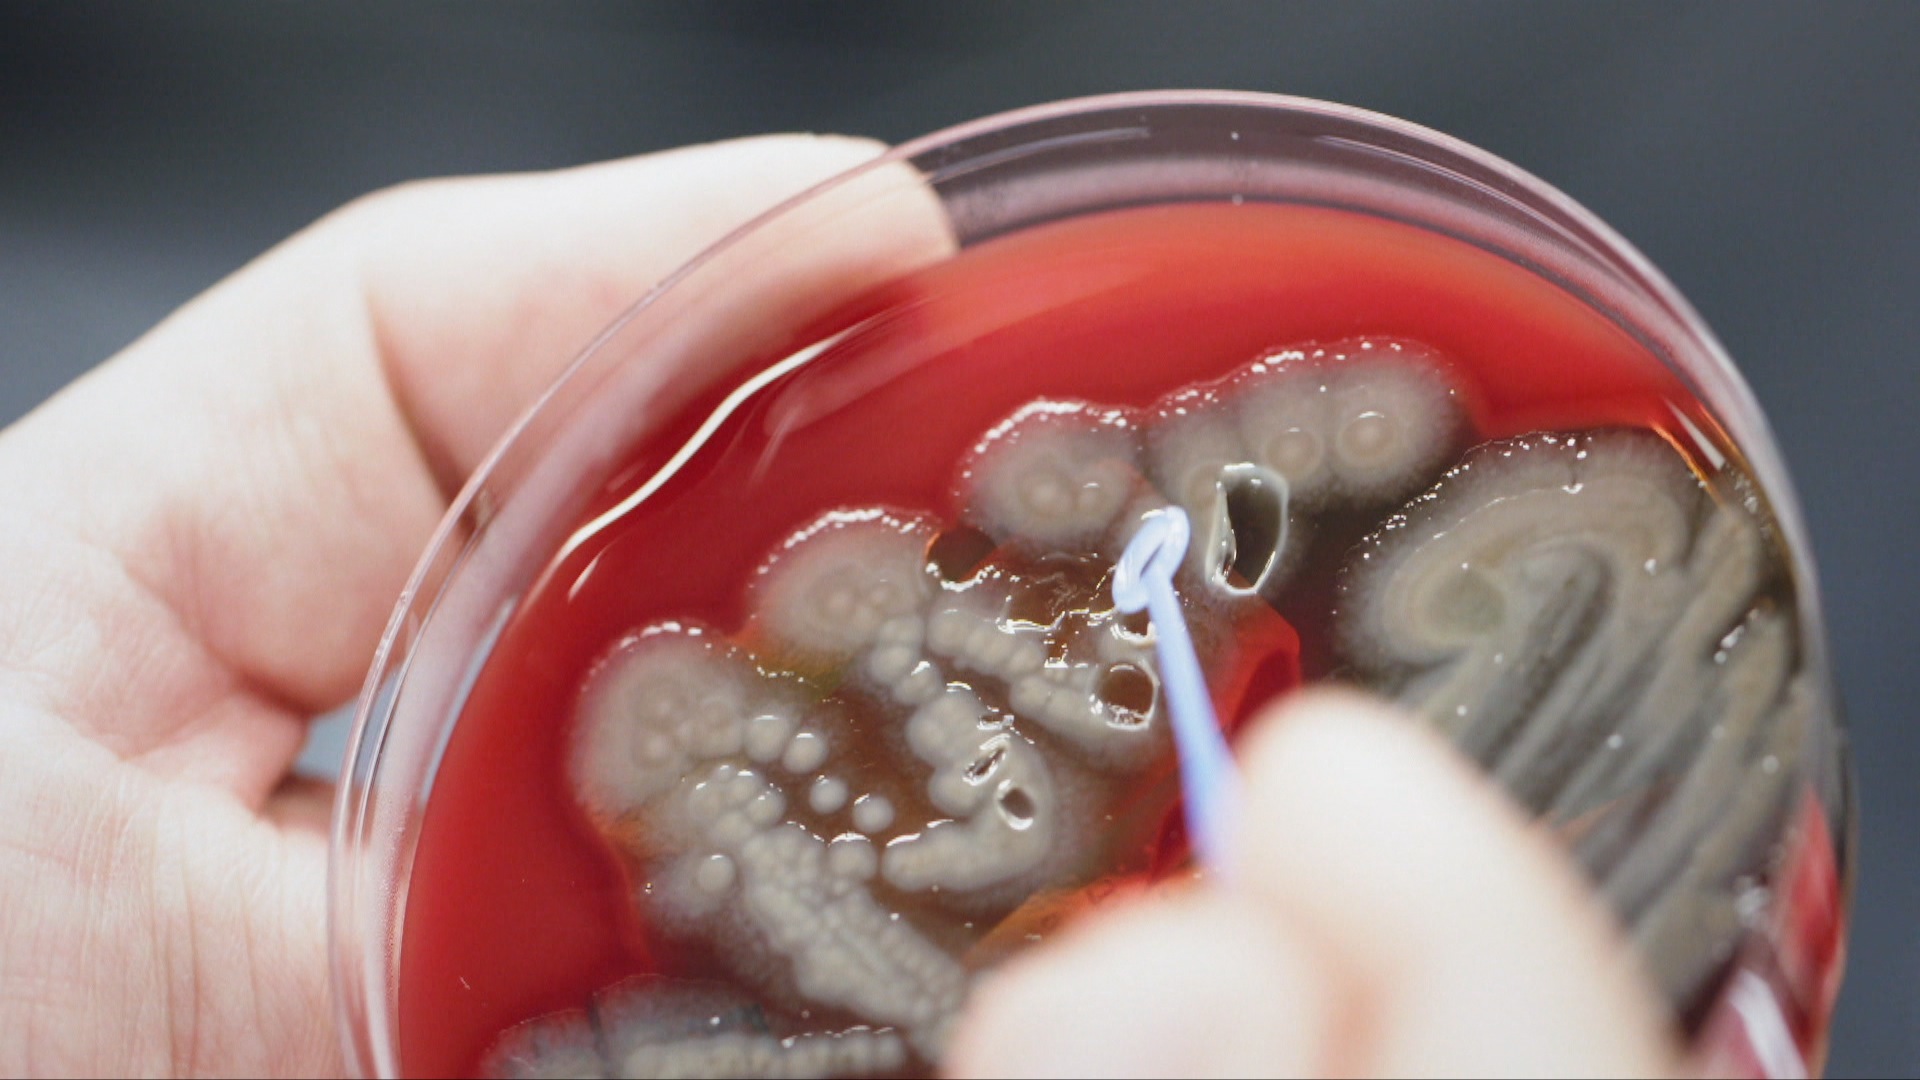

| 發表文章 | 發起投票 |
【RTHK 31】《零距離科學 3》、《危機潛藏》
本貼文共有 8 個回覆
此貼文已鎖,將不接受回覆
《31看世界》[/size=6]
安妮與阿PAUL[/size=5]
2018 年 11 月 28 日

安妮和伴侶尚保羅準備一起生活,但安妮有唐氏綜合症,尚保羅是X染色體易裂症患者,他倆能否應付?
本片以幽默方式描繪二人的日常、幸福和困難。獨特的解難方法看似行不通,卻又無傷大雅,只要兩人肯冒險同行就夠。
[#ff0818]網上重溫:尚餘 355 日[/size=4][/#ff0818]
原文及網上重溫:
http://www.rthk.hk/tv/dtt31/programme/31seetheworld/episode/535917
安妮與阿PAUL[/size=5]
2018 年 11 月 28 日

安妮和伴侶尚保羅準備一起生活,但安妮有唐氏綜合症,尚保羅是X染色體易裂症患者,他倆能否應付?
本片以幽默方式描繪二人的日常、幸福和困難。獨特的解難方法看似行不通,卻又無傷大雅,只要兩人肯冒險同行就夠。
[#ff0818]網上重溫:尚餘 355 日[/size=4][/#ff0818]
原文及網上重溫:
http://www.rthk.hk/tv/dtt31/programme/31seetheworld/episode/535917
《零距離科學》[/size=6]
暴龍再現[/size=5]
2018 年 11 月 30 日
今集將會尋找地球上超級捕獵者——暴龍的秘密。利用震驚世界的最新古生物學發現、先進技術加上與現代生物作比較,我們將重新還原暴龍真身。
是次旅程橫跨全球,由蒙大拿州的荒地,一隻暴龍從六千五百萬年前破石而出開始。在阿拉巴馬州的沼澤區,格力・艾力遜博士量度鱷魚的噬咬力量,從而推算暴龍的噬咬力量。節目又利用無人攝影機科技,展現德州的史前足跡,為暴龍步姿及步速提供有力線索。
在俄亥俄州,電腦斷層掃描提供暴龍腦袋結構的資料,以推測暴龍的智慧、感官以至社交能力。
一間位於柏林的錄音室,則根據最新研究資料,給予暴龍真正的聲音。這趟重尋暴龍之旅,將荷里活的恐龍神話打破,以驚人的事實,重新詮釋我們一向以為懂得並喜愛的暴龍。科學上最準確的暴龍,在最新電腦特技下,由骨頭開始逐步還原,讓觀眾一睹它的雄姿。
[#fc0a1a]網上重溫:尚餘 22 日[/size=4][/#fc0a1a]
原文及網上重溫:
http://www.rthk.hk/tv/dtt31/programme/sciencewithyou/episode/537667[/quote]
《31看世界》[/size=6]
委內瑞拉的噩夢[/size=5]
2018 年 12 月 05 日

成千上萬人逃離委內瑞拉,他們過境到哥倫比亞尋找工作機會、食物,卻發現自己帶來的委內瑞拉貨幣已經貶得一文不值。最終餓着肚子,在環形交通樞紐和運動場睡着。
而在委內瑞拉國內,每 100 個兒童就有 65 個營養不良,醫院和公共衛生系統完全崩潰。街上隨處可見人們翻垃圾桶,尋找食物殘渣,老人會把香蕉皮留下來,待嚴重糧食短缺時拿來充饑。
[#ff0818]網上重溫:尚餘 27 日[/size=4][/#ff0818]
原文及網上重溫:
http://www.rthk.hk/tv/dtt31/programme/31seetheworld/episode/535919
委內瑞拉的噩夢[/size=5]
2018 年 12 月 05 日

成千上萬人逃離委內瑞拉,他們過境到哥倫比亞尋找工作機會、食物,卻發現自己帶來的委內瑞拉貨幣已經貶得一文不值。最終餓着肚子,在環形交通樞紐和運動場睡着。
而在委內瑞拉國內,每 100 個兒童就有 65 個營養不良,醫院和公共衛生系統完全崩潰。街上隨處可見人們翻垃圾桶,尋找食物殘渣,老人會把香蕉皮留下來,待嚴重糧食短缺時拿來充饑。
[#ff0818]網上重溫:尚餘 27 日[/size=4][/#ff0818]
原文及網上重溫:
http://www.rthk.hk/tv/dtt31/programme/31seetheworld/episode/535919
《零距離科學》[/size=6]
超級惡菌[/size=5]
2018 年 12 月 07 日

廿一世紀對人類來說是一個大考驗,我們是否要繼續將自己的未來孤注一擲呢?
我們污染了陸地與海洋,我們的城市和街道變得擠擁不通;我們浪費食物,但同時有人要捱飢抵餓;我們更加製造出極具殺傷力的超級細菌。令自己變成無藥可救。
人類還有沒有機會扭轉劣勢呢?
[#fc0a1a]網上重溫:尚餘 29 日[/size=4][/#fc0a1a]
原文及網上重溫:
http://www.rthk.hk/tv/dtt31/programme/sciencewithyou/episode/539656
超級惡菌[/size=5]
2018 年 12 月 07 日
廿一世紀對人類來說是一個大考驗,我們是否要繼續將自己的未來孤注一擲呢?
我們污染了陸地與海洋,我們的城市和街道變得擠擁不通;我們浪費食物,但同時有人要捱飢抵餓;我們更加製造出極具殺傷力的超級細菌。令自己變成無藥可救。
人類還有沒有機會扭轉劣勢呢?
[#fc0a1a]網上重溫:尚餘 29 日[/size=4][/#fc0a1a]
原文及網上重溫:
http://www.rthk.hk/tv/dtt31/programme/sciencewithyou/episode/539656













《31看世界》[/size=6]
醜車上路[/size=5]
2018 年 12 月 12 日

本片最年輕的主角是瓦特堡 ── 一輛 50 多歲的老爺車。這輛車仍在路上行駛,70 多歲的博登 ( Bogdan ) 會載着 94 歲的母親卡茲美拉 ( Kazimiera ) 四出參加「醜車比賽」。
他們更準備遠征波德邊境,探訪父親遇難的納粹集中營和母親被囚的工廠。母子之間的關係特獨詼諧,博登幾乎把所有時間都獻給母親,照顧得無微不至,卻又鬥嘴不斷。
[#ff0818]網上重溫:尚餘 354 日[/size=4][/#ff0818]
原文及網上重溫:
http://www.rthk.hk/tv/dtt31/programme/31seetheworld/episode/539492
《零距離科學》[/size=6]
水的想像[/size=5]
2018 年 12 月 14 日

海洋、河流...水佔去地球表面七成面積。它可以改變狀態、溫度、形狀和成分,流動中的水和水壓擁有驚人的力量,它亦是萬物的起源。
然而目前為止,人類只不過開發了地球不到百分之2的水源,水仍然是非常神秘的元素。
本集,我們將會追隨那些懂得擅用水特性的科學家、以發掘地球上每一滴水為目標的工程師,並重塑我們的世界!
[#fc0a1a]網上重溫:尚餘 21 日[/size=4][/#fc0a1a]
原文及網上重溫:
http://www.rthk.hk/tv/dtt31/programme/sciencewithyou/episode/539659
水的想像[/size=5]
2018 年 12 月 14 日

海洋、河流...水佔去地球表面七成面積。它可以改變狀態、溫度、形狀和成分,流動中的水和水壓擁有驚人的力量,它亦是萬物的起源。
然而目前為止,人類只不過開發了地球不到百分之2的水源,水仍然是非常神秘的元素。
本集,我們將會追隨那些懂得擅用水特性的科學家、以發掘地球上每一滴水為目標的工程師,並重塑我們的世界!
[#fc0a1a]網上重溫:尚餘 21 日[/size=4][/#fc0a1a]
原文及網上重溫:
http://www.rthk.hk/tv/dtt31/programme/sciencewithyou/episode/539659
《31看世界》[/size=6]
糧食大變奏[/size=5]
2018 年 12 月 19 日

世界人口持續增加,糧食供應量則不斷下降。30 年後,我們的餐桌食物還剩下甚麼?
科學家不斷研究方法增加糧食供應,包括開發類似太空人進食的濃縮食品,這些食物營養豐富,免卻咀嚼時間,但我們會否因此失去享受美食的樂趣?
還有,基因改造的黃金大米、由實驗室培殖的人造牛肉,甚至昆蟲!假如這些都是我們未來的糧食,你又是否願意?
[#ff0818]網上重溫:尚餘 10 日[/size=4][/#ff0818]
原文及網上重溫:
http://www.rthk.hk/tv/dtt31/programme/31seetheworld/episode/540667
糧食大變奏[/size=5]
2018 年 12 月 19 日

世界人口持續增加,糧食供應量則不斷下降。30 年後,我們的餐桌食物還剩下甚麼?
科學家不斷研究方法增加糧食供應,包括開發類似太空人進食的濃縮食品,這些食物營養豐富,免卻咀嚼時間,但我們會否因此失去享受美食的樂趣?
還有,基因改造的黃金大米、由實驗室培殖的人造牛肉,甚至昆蟲!假如這些都是我們未來的糧食,你又是否願意?
[#ff0818]網上重溫:尚餘 10 日[/size=4][/#ff0818]
原文及網上重溫:
http://www.rthk.hk/tv/dtt31/programme/31seetheworld/episode/540667
《零距離科學》[/size=6]
汽車噩夢[/size=5]
2018 年 12 月 21 日

有數據指,至 2050 年全球的汽車數量將會達到 30 億輛,交通系統極有可能會癱瘓。面對這個難題,人類應該如何自處?
有人提出引入自動化電動車、空中巴士和真空管道,到底是否可行?
如果最終要放棄駕駛,又有沒有發明可以取代車成為我們的代步工具呢?
[#fc0a1a]網上重溫:尚餘 28 日[/size=4][/#fc0a1a]
原文及網上重溫:
http://www.rthk.hk/tv/dtt31/programme/sciencewithyou/episode/540132
汽車噩夢[/size=5]
2018 年 12 月 21 日

有數據指,至 2050 年全球的汽車數量將會達到 30 億輛,交通系統極有可能會癱瘓。面對這個難題,人類應該如何自處?
有人提出引入自動化電動車、空中巴士和真空管道,到底是否可行?
如果最終要放棄駕駛,又有沒有發明可以取代車成為我們的代步工具呢?
[#fc0a1a]網上重溫:尚餘 28 日[/size=4][/#fc0a1a]
原文及網上重溫:
http://www.rthk.hk/tv/dtt31/programme/sciencewithyou/episode/540132
| 發表文章 | 發起投票 |



